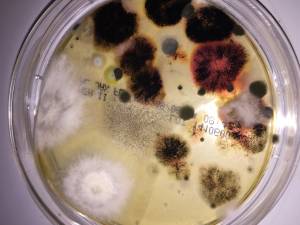
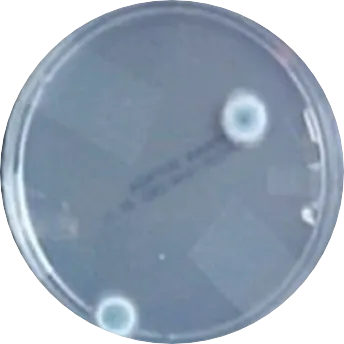

Real Results from Real People
Trusted by homeowners across the country, these are what our customers had to say.
Mold Care Made Simple
-
Lab-Accurate Results Without The Price Tag
Get professional-grade testing without the costly inspections or hidden fees.
-
Peace Of Mind In Days
Our rapid testing process gives you clear answers fast, so you can take action before mold spreads.
-
Everything You Need In One Kit
no extra trips, no missing pieces just open the box and get testing.
Your First Step Toward A Healthier Home
Skip the expensive inspections and confusing lab processes. Test for mold on your terms — safely, privately, and affordably. Take control of your indoor environment with a simple at-home kit.
Professional-level testing. Easy instructions. Real peace of mind.

Home & Safety
Reclaim Your Home, Reclaim Your Health
Mold can hide in walls, ceilings, and air vents — but it doesn’t have to stay hidden. Our lab-tested kits help you detect harmful mold fast, so you can breathe easier and feel safer in your own space.

Breathe & Live Well
Take Back Control of Your Air
Unexplained allergies? Musty smells? Don’t ignore the signs. Our at-home mold test gives you clear answers without costly inspections or appointments.

Health & Prevention
What You Can’t See Can Hurt You
Mold hides in plain sight. Our test kit helps you detect harmful spores before they affect your health or home.